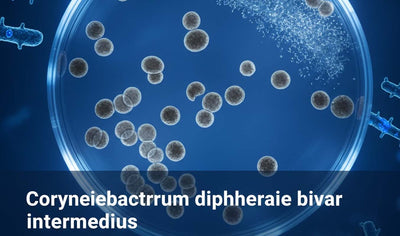

You have no items in your shopping cart.
-
Consumables & Labware
-
Equipment & Instruments
-
Cell & Molecular Biology
- Antibodies
- Buffers
- Cell Culture Media & Sera
- Colorimetric & Fluorimetric Assays
- DNA / RNA Extraction & Analysis
- ELISA Kits
- Il-6 (human)
- Inflammation cytokine; widely used in r&d
- Tnf-α (human)
- Pro-inflammatory cytokine
- Il-1β (human)
- Key mediator of immune response
- Vegf (human)
- Angiogenesis regulator
- Inf-γ (human)
- Th1 pathway cytokine
- Bdnf (human)
- Neurotrophic factor
- Insulin (human)
- Metabolic hormone
- Crp (human)
- Inflammation marker
- Gel Electrophoresis
- Pathogen Detection Kits
- Plant GMO Detection qPCR Kits
- Host Cell Residue Quantitation
- Molecular Biology Consumables
-
Reagents & Chemicals
-
Western Blot